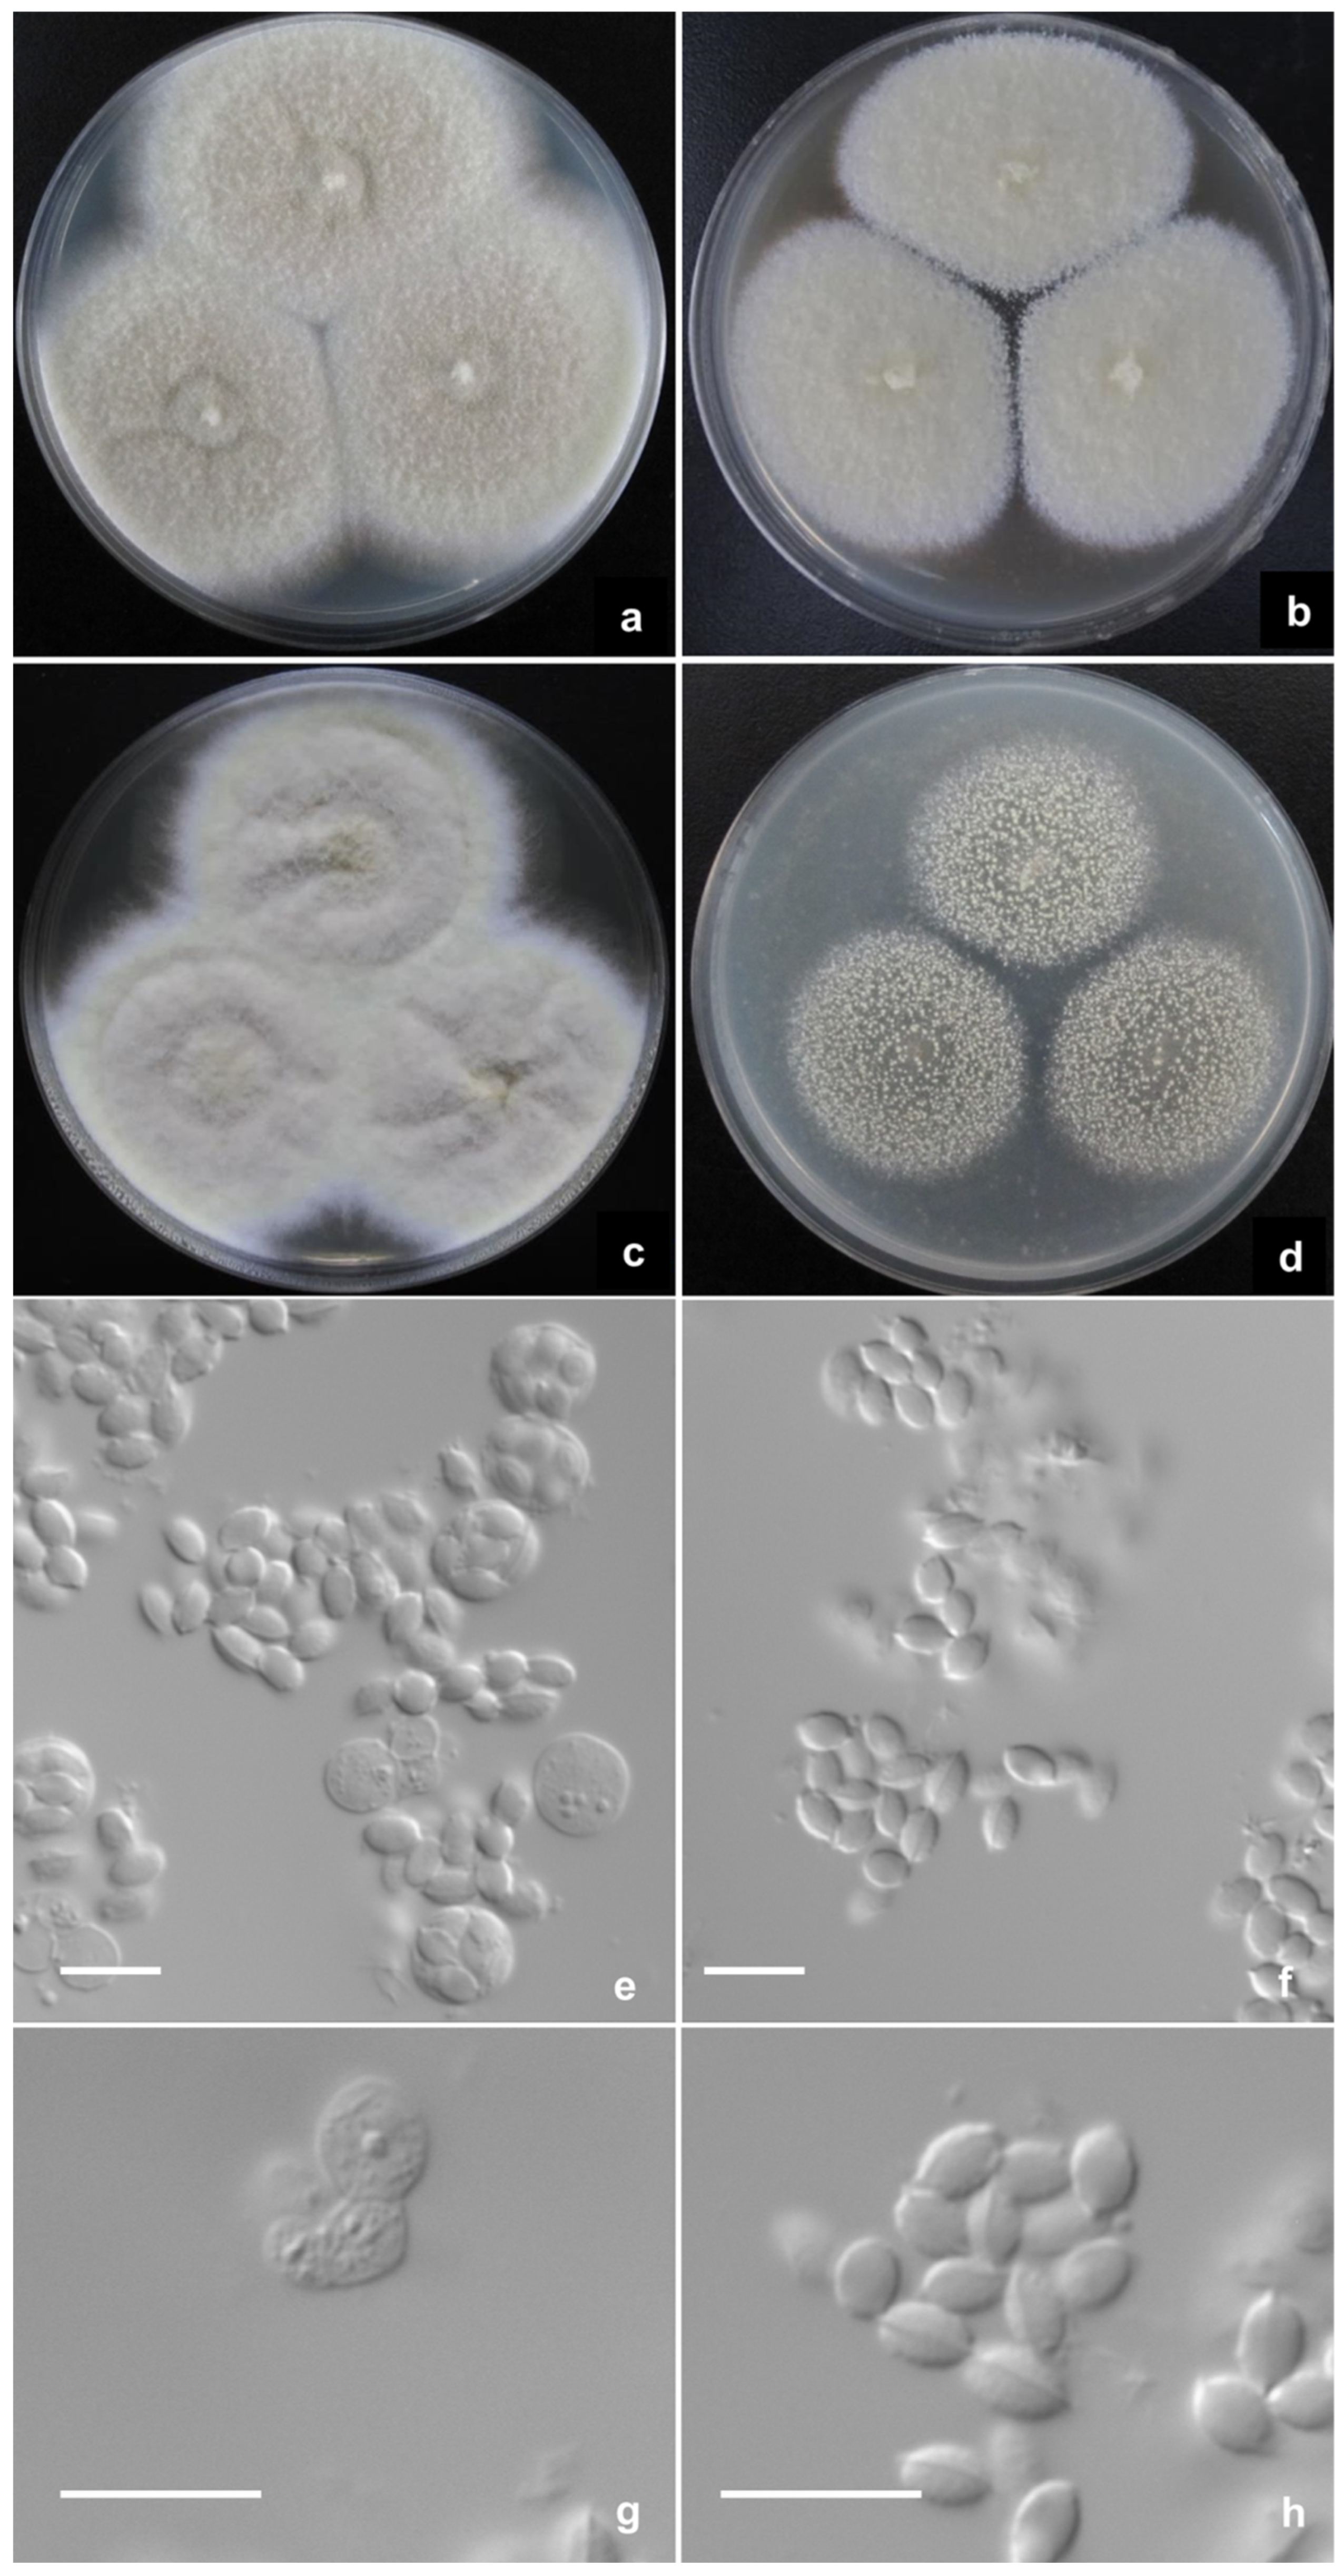

Two New Sexual Talaromyces Species Discovered in Estuary Soil in China
Abstract
:1. Introduction
2. Materials and Methods
2.1. Sampling and Fungal Isolation
2.2. Phenotypic Characterization of Strains
2.3. DNA Extraction, Amplification, Sequencing, and Phylogenetic Analyses
3. Results
Description of New Taxa
4. Discussion
Supplementary Materials
Author Contributions
Funding
Institutional Review Board Statement
Informed Consent Statement
Data Availability Statement
Acknowledgments
Conflicts of Interest
References
- Hawksworth, D.L.; Lücking, R. Fungal diversity revisited: 2.2 to 3.8 million species. Microbiol. Spectr. 2017, 5, FUNK-0052-2016. [Google Scholar] [CrossRef]
- Heo, Y.M.; Lee, H.; Kim, K.; Sun, L.K.; Kim, J.J. Fungal diversity in intertidal mudflats and abandoned solar salterns as a source for biological resources. Mar. Drugs 2019, 17, 601. [Google Scholar] [CrossRef] [PubMed] [Green Version]
- Park, M.S.; Oh, S.Y.; Fong, J.J.; Houbraken, J.; Lim, Y.W. The diversity and ecological roles of Penicillium in intertidal zones. Sci. Rep. 2019, 9, 13540. [Google Scholar] [CrossRef] [Green Version]
- Nicoletti, R.; Vinale, F. Bioactive compounds from marine-derived Aspergillus, Penicillium, Talaromyces and Trichoderma species. Mar. Drugs 2018, 16, 408. [Google Scholar] [CrossRef] [Green Version]
- Zhai, M.M.; Li, J.; Jiang, C.X.; Shi, Y.P.; Di, D.L.; Crews, P.; Wu, Q.X. The bioactive secondary metabolites from Talaromyces species. Nat. Prod. Bioprospect. 2016, 6, 1–24. [Google Scholar] [CrossRef] [Green Version]
- Nicoletti, R.; Trincone, A. Bioactive compounds produced by strains of Penicillium and Talaromyces of marine origin. Mar. Drugs 2016, 14, 37. [Google Scholar] [CrossRef] [Green Version]
- Jones, E.G.; Suetrong, S.; Sakayaroj, J.; Bahkali, A.H.; Abdel-Wahab, M.A.; Boekhout, T.; Pang, K.L. Classification of marine Ascomycota, Basidiomycota, Blastocladiomycota and Chytridiomycota. Fungal Divers. 2015, 73, 1–72. [Google Scholar] [CrossRef]
- Nicoletti, R.; Salvatore, M.M.; Andolfi, A. Secondary metabolites of mangrove-associated strains of Talaromyces. Mar. Drugs 2018, 16, 12. [Google Scholar] [CrossRef] [PubMed] [Green Version]
- Long, X.H.; Liu, L.P.; Shao, T.Y.; Shao, H.B.; Liu, Z.P. Developing and sustainably utilize the coastal mudflat areas in China. Sci. Total Environ. 2016, 569–570, 1077–1086. [Google Scholar] [CrossRef]
- Benjiamin, C.R. Ascocarps of Aspergillus and Penicillium. Mycologia 1955, 47, 669–687. [Google Scholar] [CrossRef]
- Raper, K.B.; Thom, C. A Manual of the Penicillia; Williams and Wilkins: Baltimore, MD, USA, 1949; pp. 1–875. [Google Scholar]
- Pitt, J.I. The Genus Penicillium and Its Teleomorphic states Eupenicillium and Talaromyces; Academic Press: London, UK, 1980; pp. 1–634. [Google Scholar]
- Malloch, D. The Trichocomaceae: Relationships with other ascomycetes. In Advances in Penicillium and Aspergillus Systematics; Samson, R.A., Pitt, J.I., Eds.; Plenum Press: New York, NY, USA, 1985; pp. 365–382. [Google Scholar]
- LoBuglio, K.F.; Pitt, J.I.; Taylor, J.W. Phylogenetic analysis of two ribosomal DNA regions indicates multiple independent losses of a sexual Talaromyces state among asexual Penicillium species in subgenus Biverticillium. Mycologia 1993, 85, 592–604. [Google Scholar] [CrossRef]
- Berbee, M.L.; Yoshimura, A.; Sugiyama, J.; Taylor, J.W. Is Penicillium monophyletic? An evaluation of phylogeny in the family Trichocomaceae from 18S, 5.8S and ITS ribosomal DNA sequence data. Mycologia 1995, 87, 210–222. [Google Scholar] [CrossRef]
- Wang, L.; Zhuang, W.-Y. Phylogenetic analyses of penicillia based on partial calmodulin gene sequences. BioSystems 2007, 88, 113–126. [Google Scholar] [CrossRef]
- Houbraken, J.; Samson, R.A. Phylogeny of Penicillium and the segregation of Trichocomaceae into three families. Stud. Mycol. 2011, 70, 1–51. [Google Scholar] [CrossRef]
- Samson, R.A.; Yilmaz, N.; Houbraken, J.; Spierenburg, H.; Seifert, K.A.; Peterson, S.W.; Varga, J.; Frsivad, J.C. Phylogeny and nomenclature of the genus Talaromyces and taxa accommodated in Penicillium subgenus Biverticillium. Stud. Mycol. 2011, 70, 159–183. [Google Scholar] [CrossRef] [Green Version]
- McNeill, J.; Barrie, F.R.; Buck, W.R.; Demoulin, V.; Greuter, W.; Hawksworth, D.L.; Herendeen, P.S.; Knapp, S.; Marhold, K.; Prado, J.; et al. International Code of Nomenclature for Algae, Fungi, and Plants (Melbourne Code). Regnum Vegetabile 154; Koeltz Scientific Books: Koenigstein, Germany, 2012; pp. 1–257. [Google Scholar]
- Houbraken, J.; Spierenburg, J.H.; Frisvad, J.C. Rasamsonia, a new genus comprising thermotolerant and thermophilic Talaromyces and Geosmithia species. Anton. Leeuw. 2012, 101, 403–421. [Google Scholar] [CrossRef] [Green Version]
- Yilmaz, N.; Visagie, C.M.; Houbraken, J.; Frisvad, J.C.; Samson, R.A. Polyphasic taxonomy of the genus Talaromyces. Stud. Mycol. 2014, 78, 175–341. [Google Scholar] [CrossRef] [Green Version]
- Sun, B.D.; Chen, A.J.; Houbraken, J.; Frisvad, J.C.; Wu, W.P.; Wei, H.L.; Zhou, Y.G.; Jiang, X.Z.; Samson, R.A. New section and species in Talaromyces. MycoKeys 2020, 68, 75–113. [Google Scholar] [CrossRef]
- Houbraken, J.; Kocsube, S.; Visagie, C.M.; Yilmaz, N.; Wang, X.C.; Meijer, M.; Kraak, B.; Hubka, V.; Samson, R.A.; Frisvad, J.C. Classification of Aspergillus, Penicillium, Talaromyces and related genera (Eurotiales): An overview of families, genera, subgenera, sections, series and species. Stud. Mycol. 2020, 95, 5–169. [Google Scholar] [CrossRef] [PubMed]
- Wei, S.; Xu, X.; Wang, L. Four new species of Talaromyces sect. Talaromyces discovered in China. Mycologia 2021, 113, 492–508. [Google Scholar] [CrossRef] [PubMed]
- Malloch, D. Moulds Their Isolation, Cultivation and Identification; University of Toronto Press: Toronto, ON, Canada, 1981; pp. 1–97. [Google Scholar]
- Samson, R.A.; Houbraken, J.; Thrane, U.; Frisvad, J.C.; Andersen, B. Food and Indoor Fungi; CBS-KNAW Fungal Biodiversity Centre: Utrecht, The Netherlands, 2010; pp. 1–390. [Google Scholar]
- Frisvad, J.C. Physiological criteria and mycotoxin production as aids in identification of common asymmetric penicillia. Appl. Environ. Microbiol. 1981, 41, 568–579. [Google Scholar] [CrossRef] [PubMed] [Green Version]
- Ridgway, R. Color Standards and Color Nomenclature; Published by the Author: Washington, DC, USA, 1912; pp. 1–53. [Google Scholar]
- Wang, L.; Zhuang, W.Y. Designing primer sets for amplification of partial calmodulin genes from penicillia. Mycosystema 2004, 23, 466–473. [Google Scholar]
- Glass, N.L.; Donaldson, G.C. Development of primer sets designed for use with the PCR to amplify conserved genes from filamentous ascomycetes. Appl. Environ. Microbiol. 1995, 61, 1323–1330. [Google Scholar] [CrossRef] [Green Version]
- Wang, B.; Wang, L. Penicillium kongii, a new terverticillate species isolated from plant leaves in China. Mycologia 2013, 105, 1547–1554. [Google Scholar] [CrossRef]
- Wang, L. Four new records of Aspergillus section Usti from Shandong Province, China. Mycotaxon 2012, 120, 373–384. [Google Scholar] [CrossRef]
- Jiang, X.Z.; Yu, Z.D.; Ruan, Y.M.; Wang, L. Three new species of Talaromyces sect. Talaromyces discovered from soil in China. Sci. Rep. 2018, 8, 4932. [Google Scholar]
- White, T.; Bruns, T.; Lee, S.; Taylor, J. Amplification and direct sequencing of fungal ribosomal RNA genes for phylogenetics. In PCR Protocols—A Guide to Methods and Applications; Innis, M.A., Gelfand, D.H., Sninsky, J.J., White, T.J., Eds.; Academic Press: San Diego, CA, USA, 1990; pp. 315–322. [Google Scholar]
- Hall, T.A. BioEdit: A user-friendly biological sequence alignment editor and analysis program for windows 95/98/NT. Nuc. Acids Symp. Ser. 1999, 41, 95–98. [Google Scholar]
- Tamura, K.; Stecher, G.; Peterson, D.; Filipski, A.; Kumar, S. MEGA6: Molecular evolutionary genetics analysis version 6.0. Mol. Biol. Evol. 2013, 30, 2725–2729. [Google Scholar] [CrossRef] [Green Version]
- Hall, B.G. Building phylogenetic trees from molecular data with MEGA. Mol. Biol. Evol. 2013, 30, 1229–1235. [Google Scholar] [CrossRef] [Green Version]
- Ronquist, F.; Teslenko, M.; van der Mark, P.; Ayres, D.L.; Darling, A.; Höhna, S.; Larget, B.; Liu, L.; Suchard, M.A.; Huelsenbeck, J.P. MRBAYES 3.2: Efficient Bayesian phylogenetic inference and model selection across a large model space. Syst. Biol. 2012, 61, 539–542. [Google Scholar] [CrossRef] [Green Version]
- Lee, S.Y.; Primavera, J.H.; Dahdouh-Guebas, F.; Mckee, K.; Bosire, J.O.; Cannicci, S.; Diele, K.; Fromard, F.; Koedam, N.; Marchand, C.; et al. Ecological role and services of tropical mangrove ecosystems: A reassessment. Global Ecol. Biogeogr. 2014, 23, 726–743. [Google Scholar] [CrossRef]
- Overy, D.P.; Bayman, P.; Kerr, R.G.; Bills, G.F. An assessment of natural product discovery from marine (sensu strictu) and marine-derived fungi. Mycology 2014, 5, 145–167. [Google Scholar] [CrossRef]

Publisher’s Note: MDPI stays neutral with regard to jurisdictional claims in published maps and institutional affiliations. |
© 2021 by the authors. Licensee MDPI, Basel, Switzerland. This article is an open access article distributed under the terms and conditions of the Creative Commons Attribution (CC BY) license (https://creativecommons.org/licenses/by/4.0/).
Share and Cite
Han, P.-J.; Sun, J.-Q.; Wang, L. Two New Sexual Talaromyces Species Discovered in Estuary Soil in China. J. Fungi 2022, 8, 36. https://doi.org/10.3390/jof8010036
Han P-J, Sun J-Q, Wang L. Two New Sexual Talaromyces Species Discovered in Estuary Soil in China. Journal of Fungi. 2022; 8(1):36. https://doi.org/10.3390/jof8010036
Chicago/Turabian StyleHan, Pei-Jie, Jian-Qiu Sun, and Long Wang. 2022. "Two New Sexual Talaromyces Species Discovered in Estuary Soil in China" Journal of Fungi 8, no. 1: 36. https://doi.org/10.3390/jof8010036
APA StyleHan, P.-J., Sun, J.-Q., & Wang, L. (2022). Two New Sexual Talaromyces Species Discovered in Estuary Soil in China. Journal of Fungi, 8(1), 36. https://doi.org/10.3390/jof8010036





